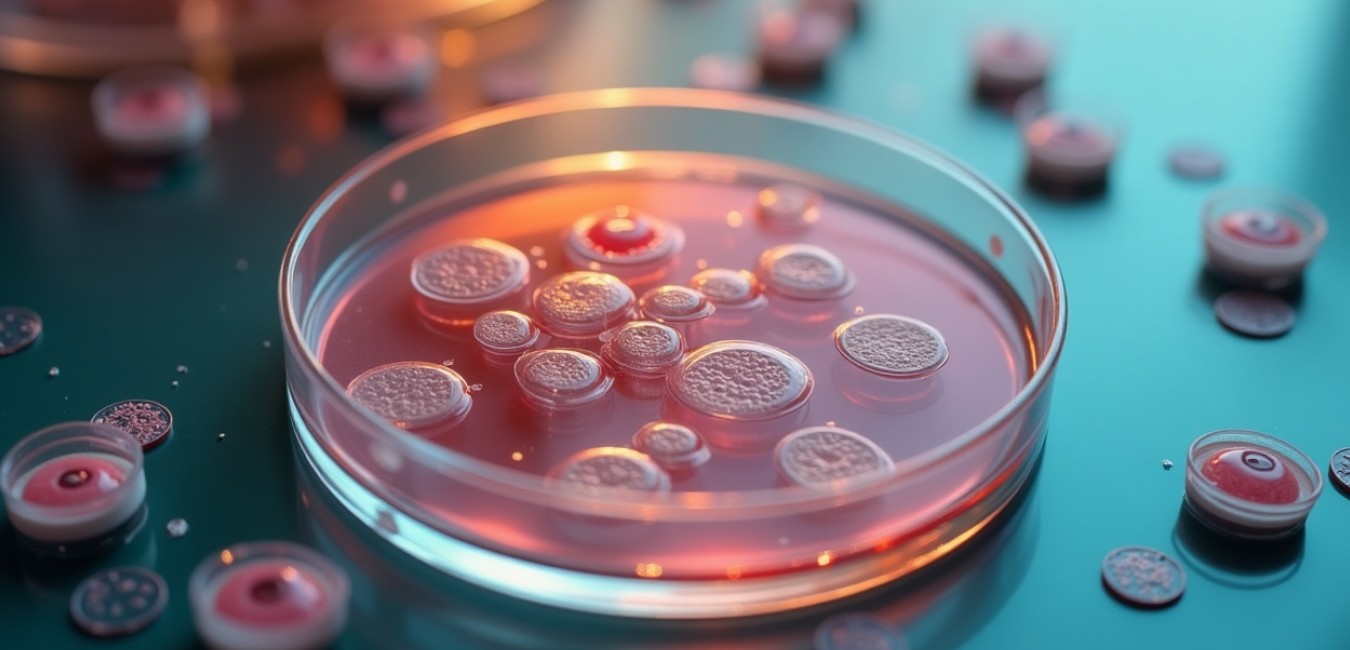
Przełom w diagnostyce oporności bakteryjnej: azytromycyna dorównuje erytromycynie

W ostatnich badaniach naukowych skupiono się na skuteczności klindamycyny, antybiotyku stosowanego miejscowo w terapii osteomyelitis związanej z implantami. Badanie to dostarcza nowych, istotnych informacji na temat zastosowania klindamycyny w praktyce klinicznej, zwłaszcza w kontekście infekcji związanych z urządzeniami ortopedycznymi. Wyniki te mogą mieć znaczący wpływ na podejście do leczenia takich infekcji, eliminując potrzebę stosowania antybiotyków systemowych.
Technologia CarboCell w leczeniu infekcji ortopedycznych
Infekcje związane z urządzeniami ortopedycznymi stanowią poważne wyzwanie kliniczne, często wiążące się z wysokimi wskaźnikami niepowodzeń terapeutycznych. Wzrost oporności na antybiotyki dodatkowo komplikuje leczenie, co skłania do poszukiwania nowych technologii dostarczania leków. W odpowiedzi na te wyzwania, badanie skupiło się na technologii depotów uwalniających antybiotyki, CarboCell, która umożliwia długotrwałe uwalnianie wysokich dawek antybiotyków w miejscu infekcji.
Formulacja klindamycyny i gentamycyny w CarboCell
Klindamycyna, w połączeniu z gentamycyną, została sformułowana w technologii CarboCell, co pozwala na strategiczne umiejscowienie leków w pobliżu zmian infekcyjnych. Klindamycyna została poddana procesowi odsalania, co zwiększyło jej rozpuszczalność i skuteczność w połączeniu z innymi antybiotykami. Technologia ta umożliwia również uzyskanie synergicznego działania przeciwbakteryjnego, co jest istotne w kontekście oporności bakterii na leczenie.
Wyniki badań klinicznych na modelu świń
Badania przeprowadzono na modelu świń z osteomyelitis związanej z implantami, co pozwala na odzwierciedlenie warunków klinicznych u ludzi. Świnie leczono miejscowo, bez użycia antybiotyków systemowych, co jest nowatorskim podejściem w terapii takich infekcji. Po trzech tygodniach leczenia zaobserwowano całkowitą eliminację Staphylococcus aureus z tkanek kostnych oraz zapobieżenie kolonizacji implantów.
Analiza mikrobiologiczna i histopatologiczna
Przeprowadzono szczegółowe analizy mikrobiologiczne i histopatologiczne, które potwierdziły skuteczność terapii. W próbkach tkanek nie wykryto obecności S. aureus, a w przypadku niektórych próbek miękkotkankowych zaobserwowano znaczące zmniejszenie liczby bakterii. Analizy histopatologiczne wykazały aktywną reorganizację kości oraz brak oznak infekcji w tkankach leczonych CarboCell.
Bezpieczeństwo i tolerancja terapii
Badania wykazały, że klindamycyna i gentamycyna były dobrze tolerowane przez tkanki kostne, a reakcje zapalne były minimalne. Co istotne, nie zaobserwowano rozwoju oporności bakterii na stosowane antybiotyki, co jest kluczowe w kontekście długoterminowej skuteczności terapii.
Dyskusja nad wynikami i przyszłe perspektywy
Wyniki badań wskazują na potencjał zastosowania technologii CarboCell w leczeniu infekcji ortopedycznych bez potrzeby stosowania antybiotyków systemowych. To innowacyjne podejście może znacząco zmniejszyć ryzyko nawrotów infekcji oraz ograniczyć rozwój oporności na antybiotyki. Dalsze badania są jednak niezbędne, aby potwierdzić te wyniki w warunkach klinicznych i ocenić długoterminowe efekty terapii.
Podsumowując, nowe badania nad klindamycyną i technologią CarboCell otwierają nowe możliwości w leczeniu infekcji związanych z implantami ortopedycznymi. Wyniki te mogą przyczynić się do poprawy jakości życia pacjentów i zmniejszenia obciążenia systemu opieki zdrowotnej związanego z leczeniem przewlekłych infekcji.
Bibliografia
Henriksen Nicole L., Serrano-Chávez Elizabeth, Fuglsang-Madsen Albert, Jensen Louise K., Gottlieb Hans, Bue Mats, Andresen Thomas L., Henriksen Jonas R. and Hansen Anders E.. Gentamicin and clindamycin antibiotic-eluting depot technology eradicates